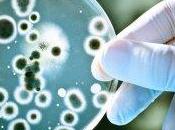
Cosa sono antibiotici?

Informasalus
 Descrizione
Descrizione
I MIEI BLOG
-
Informasalus
http://www.informasalus.it/
Da molti anni operiamo nel campo della salute, il nostro scopo è infatti quello di raggiungere il maggior numero di persone e fornire un'informazione il più possibile obiettiva e scientifica!
Oggi più che mai abbiamo bisogno di mantenerci informati e aggiornati su questi temi, considerando anche il “successo” che questi argomenti trovano nei mass-media, i quali spesso tendono a fornirci immagini contraddittorie o poco chiare di quello che in realtà sono i fatti. Prendiamo ad esempio l’inutile allarme mediatico riguardo la SARS o la più recente Influenza Suina A/H1N1.
Forti di queste convinzioni abbiamo deciso di aprire il sito informasalus.it, che cerca di raccogliere il maggior numero di articoli riguardanti svariate aree della salute, dalla medicina tradizionale a quella alternativa. Grazie all’uso delle moderne tecnologie informatiche, riusciamo poi a garantire un’ampia visibilità dei contenuti, sia su social network come facebook e twitter, che attraverso la tradizionale newsletter.
Gli articoli sono frutto delle conoscenze e dell’esperienza che gli autori hanno sviluppato negli anni esercitando la loro professione e/o ricerche. Allo stesso modo, è importante la vostra esperienza. A questo proposito, sotto ogni articolo, avete la possibilità di esprimere il vostro voto e parere, arricchendo così sia le altre persone che voi stessi.
Non ci resta quindi che augurarvi una buona lettura, nella speranza che questo progetto possa crescere e diffondersi soprattutto grazie al vostro aiuto.
ULTIMI ARTICOLI (3111)
-
Alzheimer: è epidemia. Un caso ogni 3 secondi

Nel mondo ogni 3,2 secondi una persona si ammala di demenza senile. Oggi i pazienti sono 46,8 milioni, di cui circa il 50-60% soffre di Alzheimer. Gli italiani... Leggere il seguito
Pubblicato il 04 settembre 2015 SALUTE E BENESSERE -
Alimenti che guariscono: i fichi

I fichi sono frutti squisiti, che maturano di solito tra luglio e settembre e possono essere gustati freschi o secchiI fichi sono frutti squisiti, che maturano... Leggere il seguito
Pubblicato il 04 settembre 2015 SALUTE E BENESSERE -
Bambini paralizzati in Ucraina in seguito a poliomielite

E’ quanto emerso poco fa sul sito della BBC, che riporta due casi di poliomielite dopo cinque anni dall’ultimo contagio in Europa (dati OMS). Leggere il seguito
Pubblicato il 04 settembre 2015 SALUTE E BENESSERE -
Modalità di assunzione di rimedi omeopatici nelle patologie acute

Le note che seguono riguardano essenzialmente un trattamento omeopatico unicista e cioè un trattamento prescritto da un medico omeopata che utilizza un solo... Leggere il seguito
Pubblicato il 02 settembre 2015 SALUTE E BENESSERE -
Una passeggiata al giorno allunga la vita

Passeggiare a passo svelto per 25 minuti al giorno può contribuire ad allungare la vita di ben sette anni. A sostenerlo è uno studio tedesco presentato al... Leggere il seguito
Pubblicato il 02 settembre 2015 SALUTE E BENESSERE -
Vaccini: “nuova legge mette in pericolo la salute pubblica negli Usa”

Vaccini: 'nuova legge mette in pericolo la salute pubblica negli Usa'Vaccini ancor meno controllati ed una minore trasparenza nelle informazioni fornite ai... Leggere il seguito
Pubblicato il 02 settembre 2015 SALUTE E BENESSERE -
Troppa tv? Si rischia l'embolia polmonare

Troppe ore davanti alla televisione espongono al rischio di embolia polmonare fatale, condizione generalmente associata ai voli a lungo raggio. Leggere il seguito
Pubblicato il 31 agosto 2015 SALUTE E BENESSERE -
L'inquinamento ambientale aumenta il rischio di infarto

L’inquinamento ambientale predispone alle malattie cardiovascolari allo stesso modo di fumo e ipertensione. È quanto denuncia la Società Europea di Cardiologia... Leggere il seguito
Pubblicato il 31 agosto 2015 SALUTE E BENESSERE -
La pennichella fa bene al cuore

Il pisolino fa bene alla salute, in particolare delle persone che soffrono di ipertensioneIl pisolino fa bene alla salute, in particolare delle persone che... Leggere il seguito
Pubblicato il 31 agosto 2015 SALUTE E BENESSERE -
Alimenti che guariscono: le pere

La pera è un frutto rinfrescante, tonificante, di rado causa allergie ed è un’eccellente fonte di fibraEsistono dozzine di varietà di pere; in gran parte hanno... Leggere il seguito
Pubblicato il 28 agosto 2015 SALUTE E BENESSERE -
Il succo di limone contro le infezioni gastrointestinali

Il succo di limone ci protegge dalle infezioni, riducendo la possibilità di contrarre infezioni da NorovirusIl succo di limone ci protegge dalle infezioni,... Leggere il seguito
Pubblicato il 28 agosto 2015 SALUTE E BENESSERE -
Dosi conservate male. Doppia vaccinazione per 144 bambini

Il frigo della Asl di Lodi, che conteneva alcune dosi di vaccino (per la maggior parte esavalenti) inoculate a 144 bambini, si è rotto mettendo in dubbio... Leggere il seguito
Pubblicato il 28 agosto 2015 SALUTE E BENESSERE -
Cosa sono gli antibiotici?
Una vittoria esemplare della scienza sui batteri ebbe inizio in modo assolutamente casuale...Molto probabilmente sarà capitato anche a voi che il medico vi abbi... Leggere il seguito
Pubblicato il 26 agosto 2015 SALUTE E BENESSERE -
L'agopuntura aiuta ad abbassare la pressione

L'agopuntura aiuta ad abbassare la pressione alta del sangue e a tenere sotto controllo l'ipertensione, abbassando il rischio di infarti e ictus. Leggere il seguito
Pubblicato il 26 agosto 2015 SALUTE E BENESSERE -
Gestione e trattamento della sindrome metabolica

L’obesità è stata definita clinicamente dalla “body mass index” (BMI), o indice di massa corporea, che è ottenuta dividendo il peso in Kg per i m2 dell’organism... Leggere il seguito
Pubblicato il 26 agosto 2015 SALUTE E BENESSERE -
Quattro casi oncologici canini

CATEGORIE: Omeopatia - Casi Clinici , Animali RIASSUNTOL'autore esamina quattro casi clinici arrivati alla sua attenzione perché considerati non curabili con... Leggere il seguito
Pubblicato il 12 agosto 2015 SALUTE E BENESSERE -
Un caso di artrite reumatoide trattata con Agaricus muscarius a confronto con...

CATEGORIE: Omeopatia - Casi Clinici , Omeopatia RIASSUNTOQuesto lavoro descrive un caso di Artrite Reumatoide sieronegativa (morbo di Still, AOSD) curata con... Leggere il seguito
Pubblicato il 10 agosto 2015 SALUTE E BENESSERE -
Sentenza storica: asilo espelle bambino perché vegano, il TAR lo riammette

CATEGORIE: Alimentazione , Infanzia Tutto è iniziato a febbraio. I protagonisti: un bambino vegano e una mamma consapevole!Ma andiamo per ordine. Leggere il seguito
Pubblicato il 05 agosto 2015 SALUTE E BENESSERE -
Come i conflitti di interesse hanno potuto corrompere il CDC

CATEGORIE: Denuncia sanitaria Come i conflitti di interesse hanno potuto corrompere il CDCI conflitti di interesse sono diventati più la regola che l'eccezione... Leggere il seguito
Pubblicato il 31 luglio 2015 SALUTE E BENESSERE -
I vaccini “imperfetti” rendono i virus più aggressivi

I virus possono diventare più aggressivi e pericolosi quando si usano vaccini 'imperfetti', ovvero vaccini che prevengono la malattia ma non la trasmissione... Leggere il seguito
Pubblicato il 29 luglio 2015 SALUTE E BENESSERE
